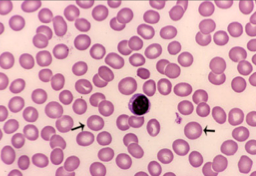
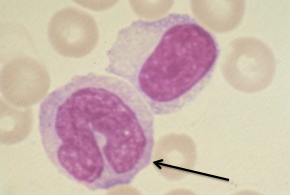
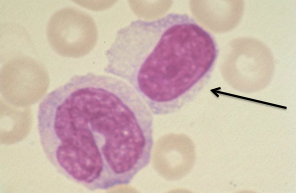
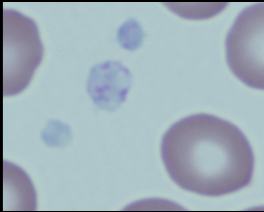
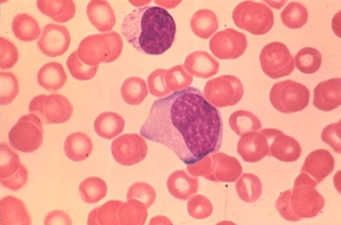
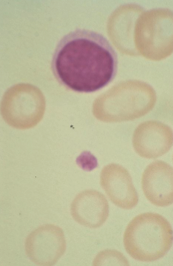
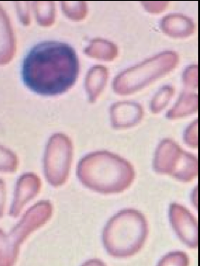
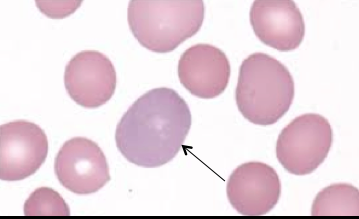
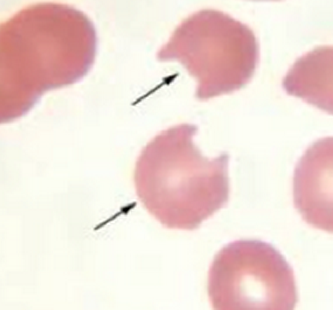
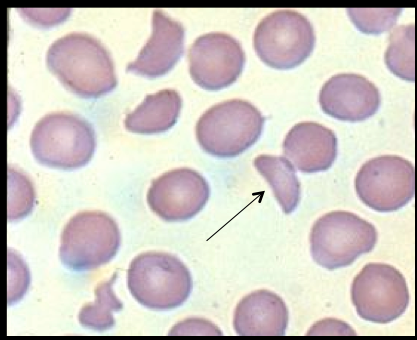
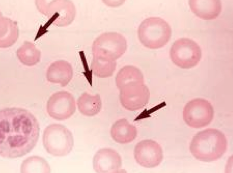
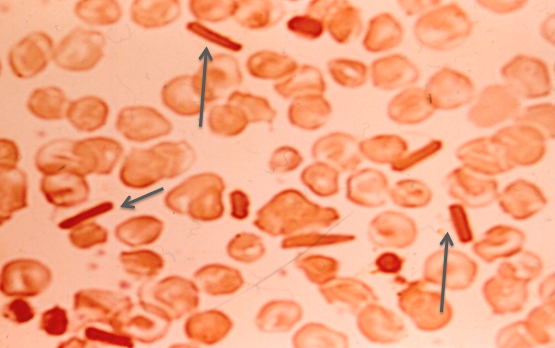
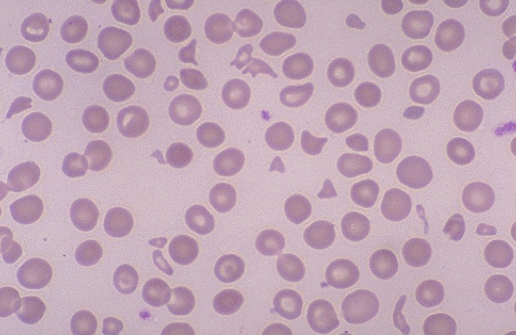

What are these?
normal RBC

eosinophil

Basophil

Neutrophil
Monocyte
Lymphocyte
Platelets
(small, aneucleate)

Band

Metamyelocyte
What is occuring in the cytoplasm of this neutrophil?

toxic granulation
reactive lymphocyte
(larger nuclei and lots of cytoplasm)
What abnormality is demonstrated by these RBC?
hypochromia
What structural abnormalities are demonstrated in these RBC?
Anisocytosis,
poikilocytosis
What abnormality is demonstrated by this cell?
Polychromasia
(residual mRNA is present in RBC)

Sickle cell
bite cells
schistocyte

Heinz bodies
bite cells

Howell Jolly bodies
Hgb C crystals
What’s the condition?

SCD Hgb SC

sickle cell anemia
What condition?
microcytic hemolytic anemia
(schistocytes)